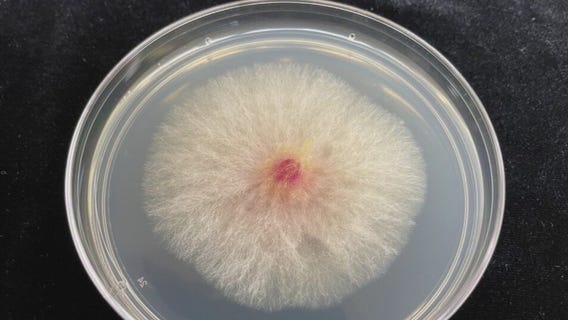
Smuggling arrests raises concerns about food supply safety

Comerica Cares and Detroit Lions team up to clean up
Comerica Bank and the Detroit Lions giving back to a Southwest Detroit Community center that did so much good for those victims in February?s massive flood caused by that giant water main break.
Student credits 'Dollars for Scholars' program for her success
Abriana Guzman, alongside her brother, is the first in her family to graduate high school. Not only that, she?s a valedictorian at Clintondale High.
Wayne County Sheriff's Office hiring blitz
Wayne County Sheriff Raphael Washington says attracting new sheriff?s deputies is much different than when he joined law enforcement more than 40 years ago.
Smuggling arrests raises concerns about food supply safety
As Chinese nationals are being investigated for allegedly smuggling biological material into the U.S., a former FBI agent is speaking out.
Project Clean Slate expunges over 15,000 records in Detroit
This week, Project Clean Slate celebrated the 15,000th expungement - giving Detroiters second chances at freedom.
Macomb Prosecutor's unusual steps to help teen in custody
The Macomb County Prosecutor's Office faced a unique legal challenge when a teen arrested for breaking and entering couldn't be housed at the Juvenile Justice Center due to a Personal Protection Order. Prosecutor Pete Lucido took unusual steps to modify the order, ensuring the teen received necessary help after escalating issues at home, including alleged assaults.
Ballot proposal would help fund Michigan schools
A plan to tax the rich to pay for Michigan's schools is not on the ballot yet - but the plan is making some noise among pollsters and stakeholder groups that believe it could be a hot-button issue.
Your car's cabin filter is more important than you think
With air quality problems mucking up Michigan's start to summer, there's ways of avoiding the worst of the breathing issues that come with pollutants. That includes in your car, where a single filter is keeping smoke and pollen from your lungs.
Taylor police add drones to 911 calls
A Metro Detroit police agency has added autonomous police drones to its force to assist with 911 calls.
MSU Settles with shooting victims
Michigan State University settled with victims of a mass shooting years ago to the tune of almost $30 million. While the case is similar to the Oxford High School shooting, the district never paid victims in its own case. Why?
New Hope's Hitting Grief Out of the Park - Free Bereavement Camp for Bereaved Children
Grief is a universal experience we all share. The way in which we experience grief, however, is unique to each person and each relationship that is lost. According to Judi?s House, Michigan has the 23rd highest concentration of bereaved children in the United States with 1 in 11 children projected to experience the death of a parent or sibling by age 18. It is imperative that bereaved children have accessible and comprehensive support to help them navigate their grief. It is imperative that bereaved children have accessible and comprehensive support to help them navigate their grief. To register your child for camp, please go to http://weblink.donorperfect.com/2025KIDSCAMP. If you are interested in volunteering or would like additional information about the camp, please visit our website at www.newhopecenter.net or call New Hope Center for Grief Support at (248) 348-0115.
Lions players join students for lesson in rapidly changing technology
The assignment was held at the Redford Service Academy, where the school?s media department interviewed the Lions players about the experience.
Another Chinese science researcher charged with smuggling bio materials at DTW
Chengxuan Han, a Chinese National, is accused of smuggling roundworms into the United States and false statements, announced United States Attorney's Office Eastern District.
Longtime Detroit radio reporter and anchor Mike Campbell dies at 65
Mike Campbell wasn't just an award-winning reporter and anchor, he was a family man, a caregiver and beloved friend who leaves a lasting legacy.
Pontiac school graduation shooting plot: Two suspects face judge
The accused suspects - Jamarion Hardiman and Deahveon Whaley were arraigned and entered not-guilty pleas in court Monday.
Mother of 4-year-old who died in crash, sentenced to jail
A distraught Shaniqua Baskin, was in a Detroit courtroom on Monday morning to face the judge.
Trump travel ban now in effect for 12 countries
Donald Trump's new travel ban is in effect for a dozen countries whose citizens are now allowed to enter the country. That includes Yemen, of which the community of Hamtramck is made up of citizens from the country.
Motor City Match recipients at ribbon-cutting ceremony Monday
Three women with eyes on building their business got a major financial lift with tens of thousands of dollars coming from Motor City Match this week.
Protesters clash with police in Los Angeles
Protests in Los Angeles continued to escalate as people clashed with local and federal police this weekend. The National Guard has since been called in, despite calls from California for the Trump Administration to back down.
Henry Ford Rochester nurses strike
Nurses at Henry Ford Hospital in Rochester are on strike over what they say are unsafe staffing levels.